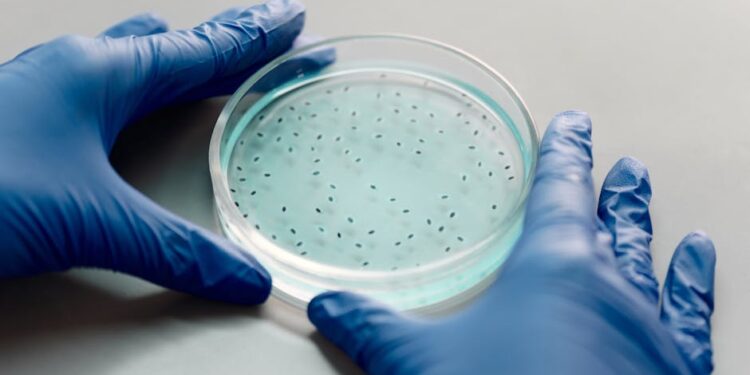
Biogen Layoffs

Biogen, a prominent player in the biotechnology sector, is undergoing significant changes that have caught the attention of the industry. The announcement of major layoffs in its research department is not just a cost-cutting exercise but part of a broader strategic shift. This article aims to provide a comprehensive understanding of Biogen’s recent decisions, the factors driving these changes, and their impact on the company’s future.
A Brief Look at Biogen
Founded in 1978, Biogen has been at the forefront of biopharmaceutical innovations, focusing on neurological diseases, hematologic conditions, and autoimmune disorders. The company has built a reputation for pioneering life-changing therapies, notably in the field of multiple sclerosis. Despite its past successes, Biogen recently faced challenges in maintaining its growth trajectory due to increasing competition and changing market dynamics.
Biogen Layoffs 2025
The wave of layoffs planned for 2025 is expected to align Biogen’s resources with its strategic focus on external collaborations and optimizing its preclinical portfolio. These layoffs follow an earlier announcement in July 2023, where the company revealed plans to cut around 11.5% of its workforce. Although exact figures for the research team layoffs have not been disclosed, the company’s intention to save $1 billion in operating expenses by 2025 illustrates the scale of the restructuring effort.
A Detailed Analysis of Biogen 2024 Layoffs
Understanding the 2024 layoffs involves assessing Biogen’s strategic realignment objectives. The company aims to invigorate its drug discovery process by forging collaborations with external entities like contract research organizations (CROs) and academic institutions. Biogen believes that concentrating resources on partnering with specialized service providers, rather than solely relying on in-house teams, will enhance innovation and ensure long-term growth.
Jane Grogan, who joined Biogen as the head of the research department in October 2023, is spearheading these transformations. Her vision of operating the research unit with a “scrappy startup” approach underscores a desire for agility and efficiency in developing new therapies. Grogan’s leadership is complemented by the appointments of Danielle Graham and Nick Wilson in key positions, enriching the new strategic direction with fresh perspectives.
Key Points Behind These Layoffs
Several factors contribute to the rationale behind the layoffs. Enhancing focus on external collaborations reflects an industry-wide trend of outsourcing aspects of the research process. Biogen aspires to leverage external expertise, gaining access to cutting-edge technologies without the full burden of in-house development costs. By reallocating resources, the company is better positioned to respond to the competitive pressures and evolving scientific landscape.
The layoffs also form part of a delicate balance between cost management and innovation. With its core franchises experiencing declining sales, especially in the multiple sclerosis segment, Biogen must optimize its operational structure to remain viable. By cutting down on its workforce, the company hopes to preserve financial flexibility while redirecting funds toward strategic initiatives.
Are Layoffs Part of a Bigger Industry Trend?
Biogen’s strategy mirrors a wider trend within the biotechnology industry. Increasingly, companies are focusing on outsourcing research and development activities to capitalize on external expertise and flexibility. This approach not only reduces operational burdens but also allows biotech firms to navigate complex regulatory environments more effectively. The trend underscores a shift from maintaining extensive in-house facilities to forming strategic partnerships, thereby driving innovation in a cost-efficient manner.
The integration of diverse scientific disciplines and the rapid pace of technological advancements mean companies like Biogen benefit from collaborating with academic and research institutions. Such partnerships foster the cross-pollination of ideas and facilitate quicker development cycles for new therapies, allowing companies to stay ahead in a competitive ecosystem.
Biogen Business Model
Biogen’s business model emphasizes R&D, but its recent restructuring efforts suggest a strategic pivot. With a focus on neurological diseases, Biogen historically relied on developing blockbuster therapies. Yet, this model faces challenges, as seen with the slow uptake of its Alzheimer’s drug, Leqembi. The revised model leans towards strategic partnerships and collaboration to fuel innovation, reducing the time and cost of delivering new treatments to market.
The shift also reflects a broader industry trend of open innovation, where collaboration opens new avenues for growth that may be unattainable through isolated efforts. By participating in collaborative networks, Biogen can explore new therapeutic domains and enter diverse markets, thus enhancing its competitive edge.
Financial Performance Of Biogen
Biogen’s financial health has been under scrutiny as its stock prices hit a five-year low. The underwhelming response to its Alzheimer’s therapy, coupled with legal disputes and declining revenues in the multiple sclerosis market, has contributed to waning investor confidence. However, the company’s cost-cutting measures and strategic realignment efforts aim to address these financial challenges by enhancing operational efficiency and driving innovation through external collaborations.
Despite these hurdles, Biogen has seen positive developments, such as the acceptance of a supplemental new drug application for a higher dose of its Spinraza therapy. These milestones highlight potential growth avenues that could fortify Biogen’s market position if managed effectively. In this context, the integration of external collaborations becomes crucial in delivering promising drug candidates to the clinic swiftly.
Lime Entrepreneur highlights the importance of aligning strategic partnerships to rejuvenate Biogen’s portfolio and secure sustainable growth in a competitive industry landscape.
Conclusion
Biogen’s recent layoffs and strategic shifts mark a significant pivot in the company’s long-standing business model. Opting for external collaborations over internal R&D reflects an adaptive strategy to manage costs while maintaining innovative prowess. Facing challenges in product uptake and market competition, Biogen’s efforts to foster partnerships with external organizations are poised to revitalise its research capabilities.
While the road ahead involves navigating financial and legal challenges, the restructuring can potentially position Biogen to unlock new opportunities and strengthen its market presence. By embracing these fundamental changes, Biogen aspires to regain investor confidence and continue its legacy of delivering transformative therapies to patients worldwide.